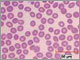

1. Even Lighting Made Simple
Ever experienced
situations where your image was not evenly illuminated?
With Vision PE's unique shading corrector feature,
you can ensure that your image is uniformly lit from
corner to corner.
|
2. Automated Mosaic
Forget tape and scissors! With the optional mosaic
feature, software automatically stitches
multiple fields to form a large image of unlimited
resolution (memory dependent). This example
demonstrates a wafer magnified at 200X with four
stitched fields.
|
|
|
|
>
>
>
>
|
use with a manual or motorized stage
for uneven surfaces, combine the
multi-layer grab function with the mosaic
feature (requires optional autofocus kit)
when running in manual mode, positioning
arrows allow you to accurately stitch
multiple fields
control the number of fields to stitch,
starting points, and more… |
3. Camera Control
With the built-in camera control
interface, when calibrating each
objective, you can adjust camera settings
including intensity, gain, and other
parameters. Once calibrated, all settings
are automically saved and you never have
to worry about manually adjusting your
lighting conditions!
I
|
4. Non-Destructive Annotations
Flexible annotation tools allow you to add
company logos, text boxes, ellipses,
squares, lines, polygons or arcs.
Properties including line thickness,
background color and opaqueness, font and
text positioning can easily be controlled
with each entity's annotation pop-up box.
Images can then be saved in industry
standard TIFF format with a
non-destructive layer where annotations
can be turned on or off.
|
5. Multiple Calibration Settings
With Clemex's intelligent
calibration feature, you can
associate a different
calibration setting for each
objective or camera. Store an
unlimited number of calibration
settings. Set it up once and
never have to worry about
calibrating your images unless
you replace your camera or
objectives! The calibration
box enables you to automatically
or manually enter calibration
parameters.
|
6. Controlling the Scale Line
smart scale line
instantly displays the correct
settings based on the chosen
magnification from the drop-down
menu box in the image window.
Controlling the look and feel of
the scale line is easily done
with the aid of the scale line
annotation window where you can
set the interval, color, and
thicknesses of the line.
|
7. Control of Input Parameters
Settings
This new set of functions allows
the user to control the
configuration parameters by
software. Camera and Light
Intensity settings can be
modified within a routine and
also microscope parameters such
as objective lens change for a
motorized nosepiece.
|
|
Camera
and Microscope Configuration
Instruction
By inserting a Select
Configuration instruction into
the prolog of a routine, the
user tells the system to load a
specific set of camera and
microscope settings to match the
corresponding image analysis
application. This is
particularly useful when
performing analyses requiring
special illumination techniques,
such as polarization,
fluorescence or DIC, this
instruction allows parameters
such as objective magnification,
white balance and shutter speed
to be preset in order to avoid
user manipulation errors.
|
8. Multi-Layer Grab
Focusing on uneven surfaces can
be troublesome. With the
Multi-Layer Grab function,
intelligent software slices your
image at varying z-intervals to
reconstruct a completely focused
image. Below is an example of an
American one cent coin magnified
at 100x with fifteen layers
sliced and reconstruction. .
|
1. Point-to-Point Direct
Measures
Whether you need to measure
perimeters, areas, lines, angles,
curve radius or any other feature
within your images, Vision
PE's robust direct measure tool set
enables you to extract the data you
need fast! Nifty features such as
controlling decimal places, location
of flag, or even color of lines can
intuitively be controlled within the
property box of the software's
direct measures.
|
2. Direct Measures in Databrowser
Need to keep a record of all your
manual measures? Vision’s
direct measure tools are dynamically
linked to the software’s
data-browser. Save or export your
results to MS Excel or other
statistical packages for further
analysis.
|
3. Rapid Routine Development
With Vision PE's intuitive
interface, you can develop image
analysis routines in a matter of
minutes. Sequentially establish a
list of image acquisition,
processing, and measurement
instructions by selecting them from
the Toolbox and see them appear in
the Routine window below. No
programming required whatsoever!
Just point and click.
|
|
Blood Cells and Cast Iron
Nodules Examples
|
|
|
|
1. Image Input
|
Loads image and applies a
Delineate filter in order to
enhance object edges. |
|
|
|
2. Threshold |
Performs an Auto-threshold
according to grey levels to
separate phases and assigns
a Bitplane color. |
|
|
|
3. Binary Transformations |
Fills holes, removes small
features and bumps from
larger objects and separates
objects. Removes objects
sectioned by the field of
view. |
|
|
|
4. Measures |
Measures length, area,
aspect ratio and sphericity
of blood cells and cast iron
nodules. |
|
4. Optional Pre-Built Imaging
Routines
Optional Application Packages
can now be purchased with
Vision PE. These packages consist of
pre-built imaging routines for
various fields of application
including materials science,
pharmaceuticals and biotechnology.
Only minimal user input is necessary
to carry out an analysis. Browse
through the thumbnails below to find
your specific area of analysis.
|
|
Phase Percent Analysis
|
|

|
|
|
|
|
|
|
|
|
|
|
Grain and Cell Sizing
|
|

|
|
|
|
|
|
|
|
Particle Sizing
|
|

|
|
|
|
|
|
|
|
|
Layer Thickness
|
|

|
|
|
|
|
|
5. Radial Grid Measure
With the radial grid measurement
function, just add the instruction
to your routine along with a bit
plane color, and extract
instantaneous ring thickness
statistics.
|
6. Volume Fraction
Whether you are analyzing 6 or 12
bitplanes, you can now extract
valuable statistical data based on
volume fraction. Raw data is
displayed in Vision’s data
browser or in summary form by way of
color coded histograms.
|
|
|
|
|